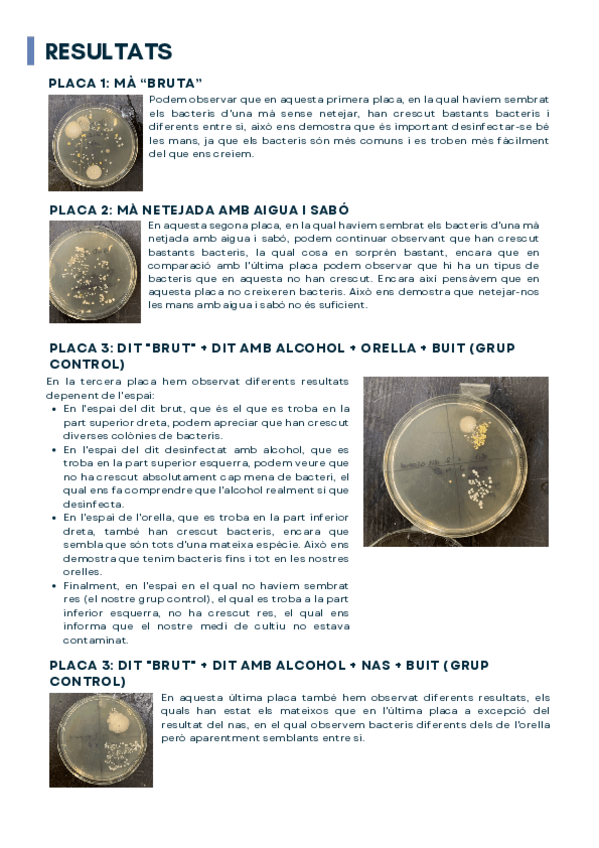

@carlagonzz_
32 Publicaciones
203 Interacciones
0 Seguidores
0 Siguiendo
Lista de publicaciones de carlagonzz_
He publicado nuevos apuntes de 2º Biología II: Formacion-de-la-vida.pdf
He publicado nuevos apuntes de 2º Biología II: Sintesis-de-Proteinas.pdf
He publicado nuevos apuntes de 2º Biología II: Respiracion-celular.pdf
He publicado nuevos apuntes de 2º Biología II: Tejidos-del-cuerpo-humano.pdf
He publicado nuevos apuntes de 2º Biología II: Sistema-respiratorio.pdf
He publicado nuevos practicas de 2º Biología II: Reaccion-aglutinacion.pdf
He publicado nuevos practicas de 2º Biología II: Nutrientes-de-la-leche.pdf
He publicado nuevos practicas de 2º Biología II: Propiedades-de-los-lipidos.pdf
He publicado nuevos practicas de 2º Biología II: Procesos-osmoticos.pdf
He publicado nuevos practicas de 2º Biología II: Cultivos-de-bacterias.pdf